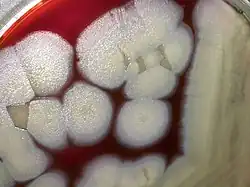

Bacillus thuringiensis
| Bacillus thuringiensis | ||||||||||||
|---|---|---|---|---|---|---|---|---|---|---|---|---|
| Systematik | ||||||||||||
| ||||||||||||
| Wissenschaftlicher Name | ||||||||||||
| Bacillus thuringiensis | ||||||||||||
| Berliner, 1915 |

Bacillus thuringiensis ist ein Bakterium, das vor allem im Boden, aber auch an Pflanzen und in Insektenkadavern gefunden werden kann. Die von dem Bakterium produzierten Bt-Toxine werden zur biologischen Schädlingsbekämpfung in der Land- und Forstwirtschaft und in der Bekämpfung von krankheitsübertragenden Stechmücken eingesetzt.
Beschreibung
Bacillus thuringiensis ist wie die anderen Arten der Gattung Bacillus stäbchenförmig und grampositiv. Er bildet Dauerstadien in Form von Sporen.
Es wurde 1901 in Japan durch Ishiwatari Shigetane (jap. 石渡 繁胤) als Bacillus sotto (von japanisch 卒倒 sottō, deutsch ‚Kollaps, Zusammenbruch‘, heute B. thuringiensis var. sotto.[1]) und 1911 von Ernst Berliner (1880–1957) in Deutschland beschrieben, der ihm den Namen Bacillus thuringiensis gab. Ishiwatari Shigetane fand den Bacillus in Seidenraupen, Ernst Berliner entdeckte ihn in Mehlmottenraupen aus einer Mühle in Thüringen. Er erkannte auch, dass dieses Bakterium bei Mehlmottenlarven die sogenannte Schlafsucht auslöst.[2] Die verschiedenen Unterarten von B. thuringiensis produzieren über 200 unterschiedliche sogenannte Bt-Toxine, die spezifisch bei bestimmten Insekten tödlich wirken.
B. thuringiensis lebt in Gesellschaft mit Pflanzenwurzeln. Es wird davon ausgegangen, dass die Toxine des Bakteriums die Wurzeln vor Schädigung durch Insekten bewahren.[3]
B. thuringiensis ist eng verwandt mit Bacillus cereus und unterscheidet sich von diesem Bakterium nur – wie auch Bacillus anthracis – durch sogenannte Plasmide. Wie alle anderen Bacillus-Arten sind sie aerob und bilden Endosporen.
Bt-Toxin

B. thuringiensis produziert kristalline Proteine (Bt-Toxine, siehe Abbildung), die spezifisch auf verschiedene Insektenarten der Ordnungen Käfer, Schmetterlinge, Hautflügler und Zweiflügler sowie Nematoden toxisch wirken, bei Pflanzen, Wirbeltieren wie z. B. Menschen jedoch wirkungslos sind. Sie sind vollständig biologisch abbaubar.[4]
Die genetische Information für die Bt-Toxine liegen auf Plasmiden. Je nach Stamm exprimieren diese ein oder mehrere verschiedene sogenannte Cry- und Cyt-Proteine, die sich hinsichtlich ihrer Toxizität gegenüber den verschiedenen Insektenordnungen unterscheiden. Es gibt mehr als 200 verschiedene Cry-Proteine. Diese toxischen Kristallproteine müssen zunächst im Insektendarm gelöst und durch eine spezifische enzymatische Abspaltung von Untereinheiten aktiviert werden, bevor sie ihre Wirkung entfalten können. Die Menge und Art der Proteine variiert hierbei von Stamm zu Stamm. Cyt- und Cry-Proteine heften sich an Darmzellen an und erzeugen Poren in der Zellmembran, wodurch die Darmzelle zerstört wird. Damit dies geschehen kann, müssen die jeweiligen Toxine spezifische Anheftungsstellen auf der Zellmembran vorfinden, woraus sich ihre spezifische Wirkung gegen bestimmte Insekten erklärt.[4]
Anwendungen
Bt-Toxine werden im Gartenbau sowie Land- und Forstwirtschaft als Pflanzenschutzmittel und zur Stechmückenbekämpfung eingesetzt. Mit ihnen können etwa Frostspanner oder Buchsbaumzünsler bekämpft werden. Da die Präparate ausschließlich gegen Schmetterlingsraupen wirken, sind andere Lebewesen nicht in Gefahr.
Landwirtschaft

In der Landwirtschaft werden Bt-Toxine seit 1938 eingesetzt, haben in dieser Form jedoch keine große Bedeutung erlangt. Hingegen wuchsen die Anbauflächen von Bt-Pflanzen seit ihrer Erstzulassung im Jahr 1996 rapide.
Bt-Suspensionen
Insbesondere in der ökologischen Landwirtschaft werden Bt-Toxine in Form von Suspensionen gegen freifressende Schmetterlingsraupen eingesetzt. Dieses Mittel wird in Frankreich seit 1938, in den USA seit 1950 eingesetzt. Heute werden verschiedene Bt-Toxine gegen verschiedene Insekten eingesetzt.[5]
B. thuringiensis israelensis (Bti) wird in der Stechmückenbekämpfung eingesetzt. Die Stechmücken werden im Larvenstadium in den Gewässern bekämpft. Die Auswirkungen auf andere Insektenlarven, beispielsweise Zuckmücken sind gering.
Andere eingesetzte Unterarten sind B. thuringiensis kurstaki (Btk), B. thuringiensis aizawai (Bta), B. thuringiensis san diego, und B. thuringiensis tenebrionis. Wie bei anderen Pflanzenschutzmitteln können nach mehr oder weniger langem Gebrauch die Zielorganismen Resistenzen entwickeln. Gegenüber Bt-Toxinen wurde dies zuerst Ende der 1980er Jahre bei der Kohlschabe beobachtet.[6]
Bt-Pflanzen
Aus Bacillus thuringiensis in Nutzpflanzen übertragene Gene bewirken, dass die Pflanzen eigenständig Bt-Toxine produzieren. Dieses sogenannte Bt-Konzept wird seit 1996 und vor allem bei Mais und Baumwolle eingesetzt.[7]
Forstwirtschaft
Eine der bisher erfolgreichsten Anwendungen von Bt-Toxinen ist die Bekämpfung von Forstschädlingen der Ordnung Schmetterlinge, welche insbesondere in nordamerikanischen Nadelwäldern große Schäden anrichten. Die Verwendung von Bt-Toxinen führte zu einer signifikanten Reduktion der Anwendung chemischer Insektizide in der Forstwirtschaft.[4] In Deutschland werden Bt-Präparate seit Jahren lokal großflächig zur Bekämpfung des Eichen-Prozessionsspinners eingesetzt.
Bekämpfung von Stechmücken
Bt-Toxine der Unterart B. thuringiensis israelensis sind für verschiedene Arten der Gattungen Aedes, Culex und Anopheles, welche Krankheitsüberträger sind, toxisch. Insbesondere lassen sich so Populationen von Überträgern von Krankheiten wie Denguefieber, Onchozerkose und Malaria dezimieren. Seit 1983 wird in Westafrika ein Programm zur Bekämpfung der Onchozerkose implementiert, das zu 80 % auf der Verwendung von Bt-Toxinen basiert. So wurden geschätzte 15 Millionen Kinder vor der Krankheit geschützt. Bei Stechmücken wurde bisher keine Resistenzbildung dokumentiert.[4]
Schädling im Garten
Auch die Bekämpfung der heimischen Gespinstmotte ist möglich. Das Bakterium wird mit Wasser versetzt vor dem Ausbruch im April auf die Pflanzen gesprüht. Da die Raupen der Gespinstmotte jedes Jahr dieselben Pflanzen befallen und kahl fressen, ist eine Prävention gezielt möglich.[8]
Taxonomie
Durch genetische Studien konnte gezeigt werden, dass es sich bei dem Biopestizid Bacillus thuringiensis, dem Milzbranderreger Bacillus anthracis und dem Lebensmittel vergiftenden Bacillus cereus um Variationen einer einzigen Spezies handelt.[9] Ob Bacillus thuringiensis auch tatsächlich Durchfall oder andere Erkrankungen verursacht, ist noch nicht abschließend geklärt.[10]
Weblinks
- N. Crickmore, D. R. Zeigler, E. Schnepf, J. Van Rie, D. Lereclus, J. Baum, A. Bravo, D. H. Dean: Bacillus thuringiensis Toxin Nomenclature. 2011 (online).
- Video: Bacillus thuringiensis (Bacillaceae) – Vegetative Vermehrung und Sporenbildung. Institut für den Wissenschaftlichen Film (IWF) 1963, zur Verfügung gestellt von der Technischen Informationsbibliothek (TIB), doi:10.3203/IWF/E-555.
Einzelnachweise
- ↑ Edward Steinhaus: Insect Pathology: An Advanced Treatise. Elsevier, 2012, ISBN 978-0-323-14317-2, S. 32 (google.com): Bacillus sotto Ishiwata [→] Taxonomic reassignment: Bacillus thuringiensis var. sotto Ishiwata. [Heimpel und Angus, 1960]
- ↑ Renate Kaiser-Alexnat (Julius Kühn-Institut, Bundesforschungsinstitut für Kulturpflanzen (JKI), Institut für Biologischen Pflanzenschutz, Darmstadt): Bacillus thuringiensis ( vom 26. Juni 2011 im Internet Archive) (PDF-Datei, deutsch; 461 kB).
- ↑ Murray W. Nabors: Botanik. Pearson Studium, ISBN 978-3-8273-7231-4, S. 354f.
- ↑ a b c d A. Bravo, S. S. Gill, M. Soberón: Mode of action of Bacillus thuringiensis Cry and Cyt toxins and their potential for insect control. In: Toxicon. Band 49, Nummer 4, März 2007, S. 423–435, ISSN 0041-0101. doi:10.1016/j.toxicon.2006.11.022. PMID 17198720. PMC 1857359 (freier Volltext).
- ↑ K. Frederiksen, H. Rosenquist, K. Jørgensen, A. Wilcks: Occurrence of natural Bacillus thuringiensis contaminants and residues of Bacillus thuringiensis-based insecticides on fresh fruits and vegetables. In: Applied and environmental microbiology. Band 72, Nummer 5, Mai 2006, S. 3435–3440, ISSN 0099-2240. doi:10.1128/AEM.72.5.3435-3440.2006. PMID 16672488. PMC 1472320 (freier Volltext).
- ↑ Bruce E. Tabashnik, Naomi Finson, James M. Schwartz, Michael A. Caprio, Marshall W. Johnson: Diamondback Moth Resistance to Bacillus thuringiensis in Hawaii. Hrsg.: Department of Entomology, University of Hawaii. (cornell.edu [PDF; 566 kB]).
- ↑ J. Romeis, M. Meissle, F. Bigler: Transgenic crops expressing Bacillus thuringiensis toxins and biological control. In: Nature biotechnology. Band 24, Nummer 1, Januar 2006, S. 63–71, ISSN 1087-0156. doi:10.1038/nbt1180. PMID 16404399. (Review).
- ↑ |Bekämpfung der Gespinstmottenraupe
- ↑ E. Helgason, O. A. Okstad, D. A. Caugant, H. A. Johansen, A. Fouet, M. Mock, I. Hegna, A. B. Kolstø: Bacillus anthracis, Bacillus cereus, and Bacillus thuringiensis–one species on the basis of genetic evidence. In: Applied and environmental microbiology. Band 66, Nummer 6, Juni 2000, S. 2627–2630, ISSN 0099-2240. PMID 10831447. PMC 110590 (freier Volltext).
- ↑ Ben Raymond, Brian A. Federici: In defence of Bacillus thuringiensis, the safest and most successful microbial insecticide available to humanity—a response to EFSA. In: FEMS Microbiology Ecology. Band 93, Nr. 7, 1. Juli 2017, ISSN 0168-6496, doi:10.1093/femsec/fix084 (oup.com [abgerufen am 23. November 2017]).